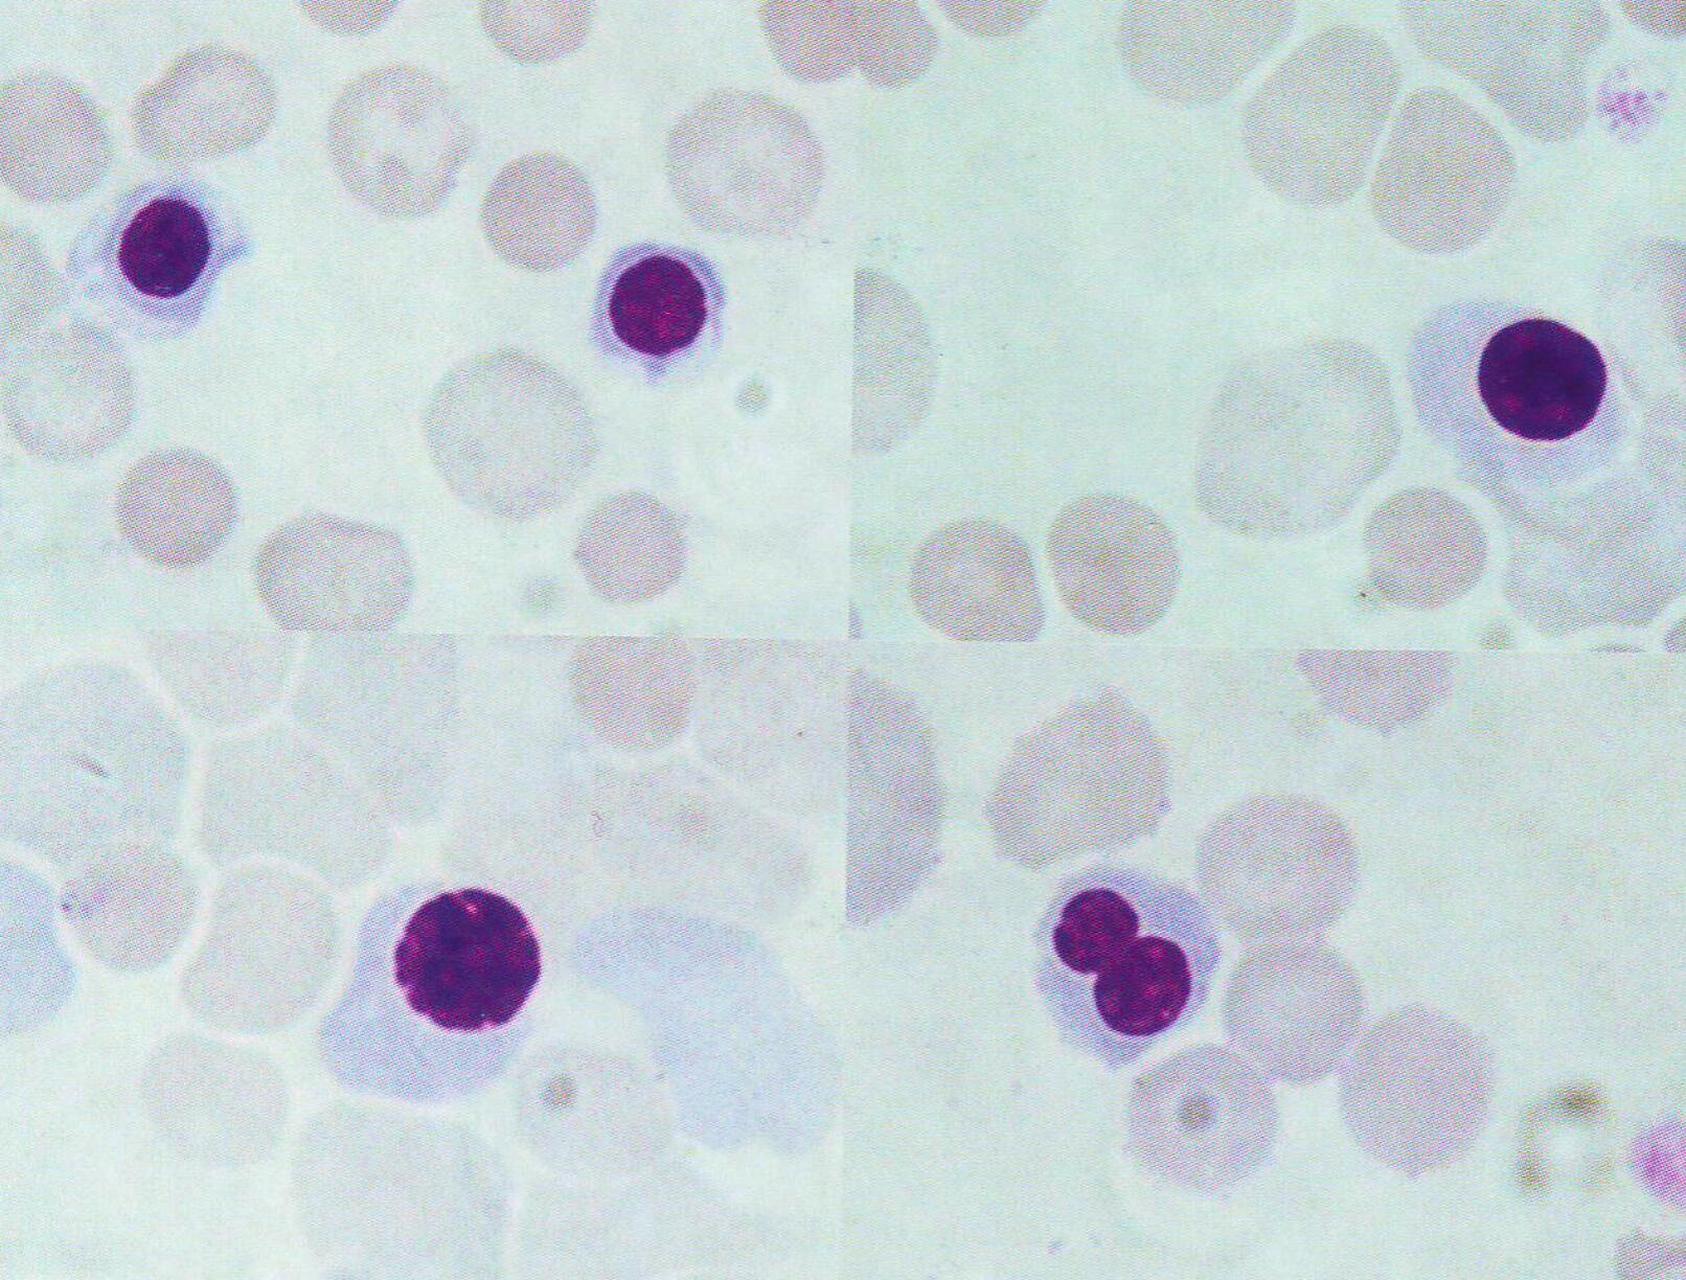
血涂片解读: 区分有核红细胞和淋巴细胞 图1是犬的有核红细胞 (瑞氏

血涂片细胞形态图谱

血涂片观察(红细胞and白细胞) 好不容易没写错字
图片尺寸1707x1280
血涂片观察(红细胞and白细胞) 好不容易没写错字
图片尺寸1280x1280
有没有红蓝铅笔血涂片的手绘图? - 知乎
图片尺寸3024x4032
有没有红蓝铅笔血涂片的手绘图? - 知乎
图片尺寸3000x2900
有没有红蓝铅笔血涂片的手绘图
图片尺寸1536x2048
一例由外周血涂片辨识出的"毛白"|骨髓|白血病|淋巴细胞|毛细胞_网易
图片尺寸660x642
1.血涂片
图片尺寸2048x1625
血涂片解读: 区分有核红细胞和淋巴细胞 图1是犬的有核红细胞 (瑞氏
图片尺寸1686x1280
临床病理学图谱血涂片中红细胞判读
图片尺寸734x553
显微镜下的血液涂片
图片尺寸1100x1100
人血涂片生物显微镜标本切片红细胞白细胞显像清晰易观察显微玻片 人
图片尺寸350x350
临检检验科血细胞形态
图片尺寸1080x821
病例分析
图片尺寸3264x2448
鸡血液各种细胞的形态
图片尺寸1500x1125
组胚血涂片图片及特点干货
图片尺寸933x1243
血涂片(这个要注意胞质染色!)复层扁平上皮单层柱状上皮
图片尺寸2048x1536![该图为血涂片,瑞氏染色,图中箭头所示的白细胞是? [图].](https://imgs.wantubizhi.com/img/A1A61BAA66193547F3A6DD7D8EE527E92DD11AAC01CF98F6DAC6638C72D8E35CE298F04E11A7BB3793AECC91A0051AFBD3519AF4CFC6AD00E7D0305018C1F9FD6B071F28F09E31CC7C64B79CCADA5BDEE62B0F3930DE9259ED9AF4F36F02692F)
该图为血涂片,瑞氏染色,图中箭头所示的白细胞是? [图].
图片尺寸729x479
组胚截图作业血涂片中的细胞
图片尺寸1080x588
3.血涂片2.疏松结缔组织铺片1.单层柱状上皮时光的掌纹865
图片尺寸1536x2048
临床病理学图谱血涂片中红细胞判读
图片尺寸721x543













![该图为血涂片,瑞氏染色,图中箭头所示的白细胞是? [图].](https://imgs.wantubizhi.com/img/A1A61BAA66193547F3A6DD7D8EE527E92DD11AAC01CF98F6DAC6638C72D8E35CE298F04E11A7BB3793AECC91A0051AFBD3519AF4CFC6AD00E7D0305018C1F9FD6B071F28F09E31CC7C64B79CCADA5BDEE62B0F3930DE9259ED9AF4F36F02692F)

![该图为血涂片,瑞氏染色,图中箭头所示的白细胞是? [图].](https://static.jiandati.com/70fde5a-chaoxing2016-383013.jpeg)


